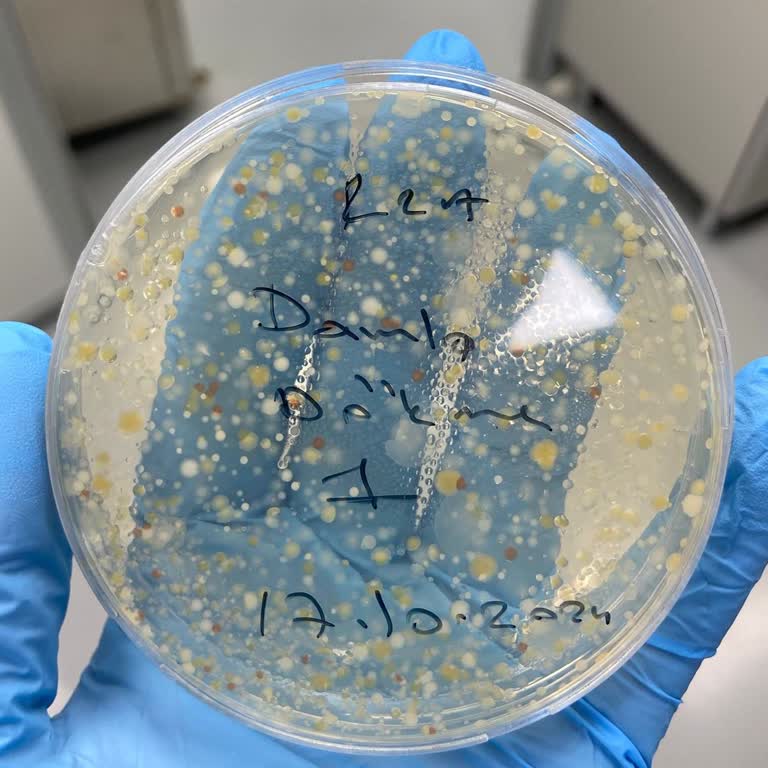
Markalı Damacanalarda Sağlık Riski İddiası

Damla Su Aldığım Suda Yabancı Madde Çıkması Ve İşletmenin İlgisizliği

Isparta Atabey ilçesi Ertokuş Medresesi içindeki belediye tesisinden Damla Köyceğiz su aldım. İçerken ağzıma silikona benzer bir madde geldi. Suyun dolumu nasıl yapılıyor, suyun içinden nasıl yabancı madde çıkabiliyor, anlamıyorum. Suyu aldığım işletmeye durumu ilettim, 'Biz ne yapalım' şeklinde ilg...